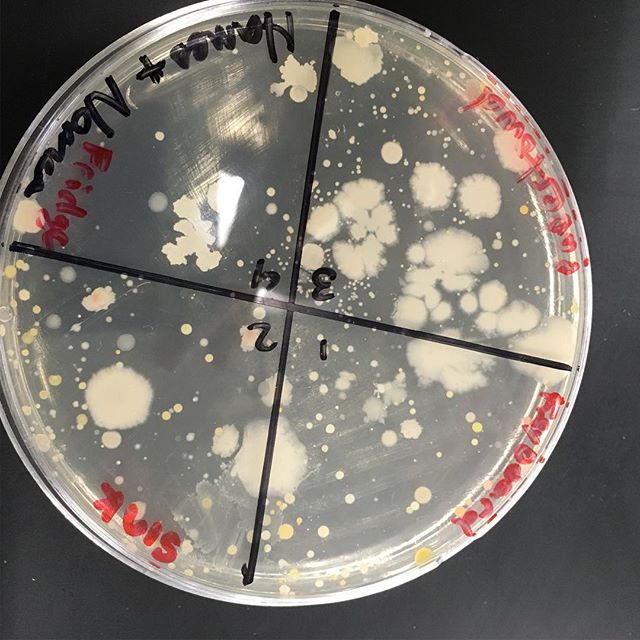

Your yearly reminder to wash your hands! Biology 11 found bacteria everywhere
Amanohashidate 天橋立 . #stealingdaylight #kyoto #miyazu #amanohashidate #scenery #pine #shore #coastline #japan #japantravel #japanscenery #vscocam #travel #nikon #nikonphotography #d750 #photography #instagood #instatravel #potd #hkig #pbhk #日本 #京都 #宮津 #天

MIHO MUSUEM 美秀美術館 Blog: stealingdaylight.com/miho-museum . #stealingdaylight #mihomusuem #shiga #art #musuem #gallery #impei #architecture #japan #japantravel #japanesearchitecture #contempary #vscocam #travel #nikon #nikonphotography #d750 #photography #

Kurashiki Bikan Historical Quarter 倉敷美観地区 . #stealingdaylight #okayama #kurashiki #oldtown #canal #willow #sunset #japan #japantravel #japanesearchitecture #vscocam #travel #nikon #nikonphotography #d750 #photography #instagood #instatravel #potd #hkig
